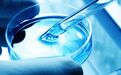
君实生物赴港上市：港股IPO新政首年生物医药公司补血或达200亿

港股上市新规吸引了不少生物医药企业赴港IPO。
公开信息显示:今年4月,港交所发布了新修订的《新兴及创新产业公司上市制度》,允许未通过主板财务资格测试的生物科技企业上市。
根据相关文件,生物科技企业在港股IPO的门槛大幅降低,只要满足产品受主管当局规管、已通过临床一期实验且获准开始二期或其后阶段的试验、最少一名资深投资者做出相当数额的投资这三条,即可界定为适合上市。
新规发布之后,生物科技类公司迅速行动,到10月底,已经有四家公司成功在港股IPO,融资总额超过150亿港元。
另外还有一众公司在近期提交了聆讯资料集,包括:君实生物、盟科医药等,根据各家聆讯资料集披露的信息估算,如果能够在年内完成发行,今年根据上市新规在港股上市的生物科技公司,募资总额可能会超过200亿港元大关。
今天主要解读其中的君实生物。先回溯一下已经上市的四家生物科技公司的市场融资情况与市场表现。
新规半年:亏损生物医药公司扎堆赴港上市
到目前为止,新政实施了六个多月,已经有4家生物科技企业获准在港交所上市,分别是歌礼制药、百济神州、华领医药以及信达生物。
上市的这四家企业去年均录得亏损,其中的百济神州亏损最大,达到0.96亿美金,但募资金额都不小,总额超过150亿港元。首家上市的歌礼制药募资约31.38亿港元,募资金额最小的华领医药金额也接近9亿港元,募资金额最高的百济神州高达70.85亿港元。
不过,已经渡过股价稳定期的几家公司,股价表现均不佳,其中歌礼制药至今跌幅已达50%,百济神州跌幅超过了20%。虽然信达生物表现较强,但由于公司上市还不到10个交易日,未来还需观察。
君实生物此前已经提交了聆讯资料,或许不久就会成为港股生物科技板块的一名新兵。与已经上市的四家公司相比,君实生物有不少共同点也有一些独特之处。
其中一个最大的共同点在于,此前投入巨额资金用于研发,目前仍处于亏损之中。
研发“烧钱”:两年亏损4.53亿,亟待融资补血
公开资料显示,君实生物成立于2012年,主营创新药的发现、研发、临床研究以及商业化,目前的核心研究领域包括癌症、心血管疾病以及自身免疫疾病。2015年,公司在新三板挂牌上市,同年重磅药物JS001通过了关于开展新药临床研究的申请,目前该药已经处于新药注册受理阶段。
目前,公司还没有重磅产品上市,收入规模较小。但是,随着研发推进,公司需要大额的研发、行政等支出,公司业绩持续亏损。
2016年和2017年,公司的研发开支分别为1.22亿和2.75亿,亏损额分别为1.32亿元及3.21亿元,合计4.53亿。截至2018年4月底,公司研发开支达到了1.22亿,同比去年大增96.77%,期内亏损约1.59亿元。
高强度的研发支出,资金从什么地方来呢?公开资料显示,截至公司披露上市聆讯资料集的日期,公司已进行了五轮股票发行,募资总额达12.68亿。同时,公司还在今年2月份发行了金额为2亿人民币的可换股债券,年利率达到了10.35%。
从资产负债表可以看到,截至2018年6月底,公司账上的其他金融资产和银行结余及现金的总额为4.76亿。按照公司2017年研发支出2.75亿测算,还可以满足公司约21个月的研发费用。如果公司上市募资成功,资金压力将大为缓解。
在研管线丰富,行业竞争激烈
公司耗费巨资所打造的研发管线究竟如何?
截至递交聆讯资料集的日期,公司的核心管线包括13项在研生物药品,其中肿瘤领域占据7项,其他分别针对代谢疾病、自身免疫以及神经性疾病。4项在研药品获得了CDA(国家药品监督管理局)的新药临床申请,其中的一项已提交新药上市申请。
下图为公司的生物药研发进度:
以公司进度最快的JS001为例,该药是一款针对检查点抑制剂PD-1的免疫疗法药物,目前针对黑色素瘤2线治疗的临床进度最快。此外,公司针对该药正在开展的适应症还包括鼻咽癌、胃癌以及食管癌等。
全球来看,目前只上市了两种PD-1抑制剂以及三种PD-L1抑制剂,前者分别为默克的Keytruda以及百时美施贵宝的Opdivo(俗称OK药),Opdivo和Keytruda这两款药物分别在今年6月和7月获批国内上市。
根据聆讯资料,全球PD-1及PD-L1抑制剂销售额从2015年的16亿美金上升到了2017年时的101亿美金,复合增速达到了154.2%,预计2017年至2022年复合年增长率为29.3%,市场规模预计在2030年达到789亿美元。
根据聆讯资料,国内PD-1及PD-L1抑制剂市场仍处于发展初期,PD-1及PD-L1抑制剂的市场规模预计将于2018年至2022年期间以534.4%的复合年增长率增长至2022年的374亿人民币。
在国内药企中,君实为第一家获批PD-1药物国内临床实验的公司,目前进度领先。但是,由于PD-1药物巨大的市场空间,众多公司加入竞争。除了已经获批国内上市的两家国际药企,国内已经有三家公司提交了新药上市申请,预计都将在2019年获批上市。
除了PD-1药物,公司目前临床进度领先的产品还包括JS002(PCSK9) 、UBP1211(TNF-α)以及UBP1213(BLyS),三者分别针对高胆固醇血症、类风湿性关节炎以及系统性红斑狼疮。
销售能力或是短板
销售能力对医药公司也相当重要。但是从目前公司的人员构成来看,公司的销售能力不强。
截至2018年4月底,公司有347名员工,其中研发和生产的员工占比均超过30%。但是,公司的管理、行政与营销人员只有60人。
随着未来公司产品的不断获批上市,销售人员的数量难免会捉襟见肘。若相关竞品均能实现上市,未来与公司PD-1产品同台竞争将是恒瑞医药这样的国内大药企,而后者拥有成熟的销售团队。
根据公司公开资料,公司针对这一问题给出的解决方案一是增加销售人员的招募,二是寻找外部第三方进行销售合作。但是,通过第三方的销售合作难免会降低公司的主动权以及减少公司从该类药品中所能获取的收入。
从政策层面来看,国家不断出台鼓励创新药发展的政策,港交所允许未盈利生物科技企业上市。那么,生物药市场到底有多大?
4000亿美元生物药市场:谁会拔得头筹?
港交所修订上市规则,为亏损的生物科技医药公司开设“特殊通道”,实际上也是在押注于生物制药这一巨大的潜力市场。
生物药包括单克隆抗体、重组蛋白、疫苗及基因和细胞治疗药物。
根据君实生物的聆讯资料集显示,2017年全球十大畅销药物中,八种为生物药,其销售总额达到了678亿美金,占所有十大畅销药物总收入的82.5%。同时,公司报告还预计2017年至2022年全球生物药市场规模将从2402亿美金上升到4040亿美金,复合增速达到11%。
公司资料显示,中国的生物药市场虽然规模相对较小,但增速更快,预计整体规模将从2017年时的2185亿人民币上升到2022年的4785亿人民币,复合增速达到17%。
生物药市场规模庞大且仍在快速增长,而国内生物企业在政策、资本的加持下近年也获得了巨大的进步。但是,由于生物科技企业需要在前期进行大量的研发、设备投入,大部分企业仍处于亏损状态。能获得持续补血或率先实现盈利的企业更具优势。
生物制药是个水大鱼大同时又风高浪急的市场,一旦重磅药占领市场有可能催生大牛股;但研发过程不仅耗费巨资,市场竞争也充满不确定性,一旦压错宝亦可能损失惨重。
本文作者:面包财经
免责声明:本文仅供信息分享,不构成对任何人的任何投资建议。
“特别声明:以上作品内容(包括在内的视频、图片或音频)为凤凰网旗下自媒体平台“大风号”用户上传并发布,本平台仅提供信息存储空间服务。
Notice: The content above (including the videos, pictures and audios if any) is uploaded and posted by the user of Dafeng Hao, which is a social media platform and merely provides information storage space services.”